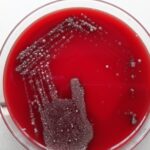

Tag: Infectious disease diagnosis
Synovial Fluid Culture and Sensitivity Test-Introduction, Report, Clinical Significance, Common Pathogens, and Keynotes
 Introduction A Synovial Fluid Culture and Sensitivity Test is a...
Introduction A Synovial Fluid Culture and Sensitivity Test is a...
Throat Swab Culture and Sensitivity Test-Introduction, Report, Clinical Significance, Common Pathogens, and Keynotes
Introduction The Throat Swab Culture and Sensitivity Test, also known...
Introduction The Throat Swab Culture and Sensitivity Test, also known...
Nasal Swab Culture and Sensitivity Test-Introduction, Report, Clinical Significance, Common Pathogens, and Keynotes
 Introduction The Nasal Swab Culture and Sensitivity Test is a...
Introduction The Nasal Swab Culture and Sensitivity Test is a...
